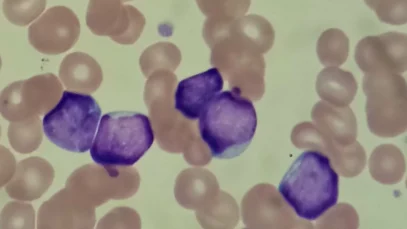
linfoblastos-wide_webp

Lazos del amor | Película completa | Película romántica en Español Latino
Lazos del amor | Película completa | Película romántica en Español Latino Quince años de matrimonio feliz terminan inesperadamente debido al hecho de que Svetlana fue promovida en el trabajo, y su esposo Vlad todavía trabaja como plomero y no quiere desarrollarse. Svetlana quiere que su esposo se convierta en empresario, pero Vlad no comparte […]